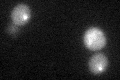
YDR267C

View description
WD40 repeat protein involved in assembly of cytosolic and nuclear iron-sulfur proteins; similar to the human Ciao1 protein; YDR267C is an essential gene
Localization:
Intensity:
Fold change:
Significance:
-
C’ GFP library in SD

cytosol21.83 -
N' NOP1pr-GFP in SD

cytosol,nucleus104.933 -
N' TEF2pr-mCherry in SD

nucleus135.023 -
N' NATIVEpr-GFP in SD

cytosol33.6292 -
N' TEF2pr-VC and Cyto-VN in SD

cytosol45.0008 -
C’ GFP library in SD+DTT
cytosol20.170.92No -
C’ GFP library in SD+H2O2

cytosol25.891.18No -
C’ GFP library in Starvation Media

cytosol24.581.12No -
C’ GFP library on the background of Pup2-DaMP

cytosol -
C’ GFP library on the background of CCT mutant

cytosol22.86441.04716No
